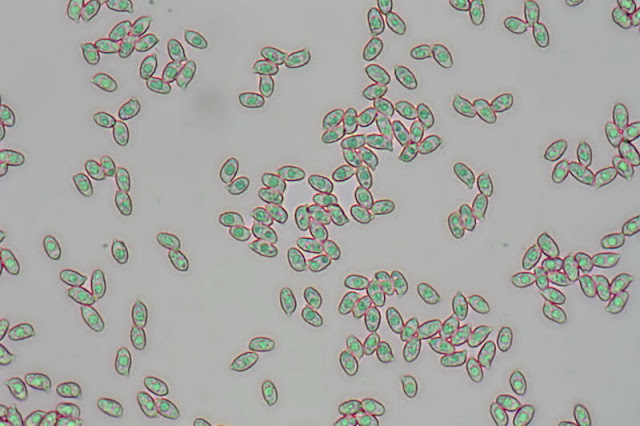

Pequeña ramaria o patita de rata muy típica de pinares y otros bosques de Coníferas, con tronco fino, ramas erguidas, coloración ocrácea, de sabor amargo y por tanto incomible y un suave pero neto olor anisado. VER DESCRIPCIÓN COMPLETA.
El himenio o superficie
fértil recubre las ramificaciones cilíndricas, erectas y divididas
dicótomamente que terminan en una o varias puntas, al principio de color
amarillo ocráceo claro y luego pasan a ocre-amarillento con algunos reflejos
rosados por las esporas.
En una sección transversal de una de las ramificaciones se aprecia la trama interna muy regular y la superficie diferenciada por los basidios, basidiolos y las esporas que producen.
La carne o trama del carpóforo es de tipo dimítica formada por dos tipos de hifas, la mayor parte generativas, de paredes finas y provistas de tabiques dispersos y las esqueléticas, mucho más escasas, con paredes muy gruesas y sin tabiques.
Las hifas generativas son las que producen en superficie los basidios y basidiolos, presentan paredes delgadas y presentan tabiques con gruesos abultamientos, las fíbulas, de gran importancia taxonómica.
Las hifas generativas más superficiales dan lugar a células terminales perpendiculares a la superficie que tapizan todas las ramitas del carpóforo.
Los basidios y basidiolos
son muy alargados y progresivamente ensanchados hacia la extremidad, donde
terminan en dos o cuatro pedúnculos, los esterigmatos, en cuya extremidad se
forman las esporas.
Observados en rojo congo más separados por presión se aprecia mejor la longitud de estas estructuras y su terminación redondeada en los basidiolos y algo más anchos y claviformes en los basidios con los esterigmatos.
Aunque la mayor parte delos basidios producen cuatro esporas, tetraspóricos, en la extremidad de otros tanto esterigmatos, algunos solo presentan dos esterigmatos y producen solo dos esporas, bispóricos.
Una ramificación dejada durante unas horas sobre una superficie deja una mancha ocrácea clara formada por innumerables esporas que se producen en toda su superficie.
Las innumerables esporas que se producen en toda la superficie de las ramificaciones son incoloras o muy sutilmente amarillentas al microscopio, pero ocráceas en masa como aparecen en el portaobjetos y oscurecen muy ligeramente los carpóforos en la madurez.
Las esporas son
elipsoidales, de paredes ligeramente verrugosas y con una pequeña prominencia
en uno de los extremos, el apículo, por donde se sujetaban al basidio.
Todas las ramificaciones proceden de un pie basal más o menos cilíndrico o un poco aplastado que presenta una base miceliar o algodonosa blanca con algunas prolongaciones a modo de raíces, rizoides.
La carne o trama del pie es similar a la de las ramificaciones, fundamentalmente monomítica, formada por hifas generativas, muchas de las cuales presentan abultamientos o engrosamientos junto a los tabiques.
Por el contrario, los rizoides que surgen de la base y que se introducen en el suelo están constituidos por ramilletes a agrupaciones de hifas fundamentalmente esqueléticas, mucho más consistentes, por supuesto mezcladas con hifas generativas.
Las hifas esqueléticas
que forman los rizoides son más finas que las del resto del carpóforo, muy poco
ramificadas y sin tabiques, entre las cuales destacan las hifas generativas, de
similar grosor, pero provistas de tabiques con engrosamientos o fíbulas.